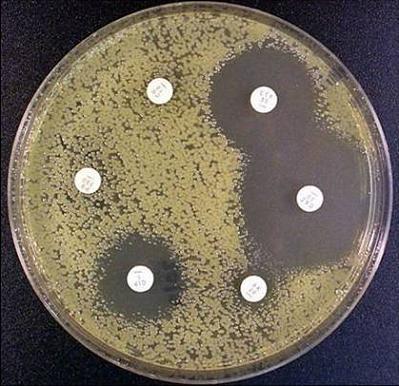
产品封面图

相关产品推荐更多 >
万千商家帮你免费找货
0 人在求购买到急需产品
- 详细信息
- 文献和实验
- 技术资料
- 保质期:
一年
- 英文名:
0
- 库存:
1000
- 供应商:
青岛捷世康
- CAS号:
NO82419-36-1
- 保存条件:
常温
- 规格:
5g
我们拥有富有经验的研究团队与先进的生产设备。与国内国际著名实验室保持良好的合作与交流。致力于生产
稳定高效的产品以及提供优质的服务。生产产品及代理品牌产品范围涵盖了分子生物学、细胞生物学、细菌学
、遗传学、免疫学、生物化学、蛋白质学等生命科学相关领域及相关实验室消耗品。
产品名称:氧氟沙星
产品规格:5g
产品编号:BS7098
抗生素的使用原则:
1.不适宜过早使用抗生素进行“试验治疗”。因为其盲目性大,不对症用药更有害无益。发热原因不明者
不宜用抗生素,因为抗生素会使致病菌无法检测,导致临床表现不典型,影响确诊,延误治疗(危重患者及高
度怀疑细菌感染者除外)。
2.不要随意把抗生素作为预防感染用药使用。
3.严格按量、按疗程用药,随意中断、频繁更换等不规律用药都对患者不利。老年人、儿童以及肝、肾功
能不良者等人群,应酌情减量并且缩短用药时间。
4.非严重细菌感染引起的皮肤、黏膜疾病等,尽量避免局部外用抗生素,以免发生过敏现象。
5.掌握适应症,有严格的用药指征。抗生素对各种病毒性感染和非细菌性发热并无多大疗效,对麻疹、腮
腺炎、伤风、流感等患者给予抗生素治疗更有害无益。90%以上的咽喉炎、上呼吸道感染者是由病毒引起,除
能确定为细菌感染者之外,一般不宜使用抗生素。
6.掌握药物的不良反应,用药前做药敏试验,提倡细菌检测,针对所感染细菌对症下药。
7.联合用药的指征是:病情危重(如败血症)或多种细菌混合感染,一般以两种为佳。
公司其他优势产品:
改良克氏双糖铁培养基 生化培养基,用于小肠结肠炎耶尔森氏菌的生化反应筛选
改良Y培养基 用于分离小肠结肠炎耶尔森氏菌 (GB标准)
ITC肉汤 用于分离培养耶尔森氏菌(ISO方法)
SSDC培养基(ISO) 用于小肠结肠耶尔森氏菌的分离培养
CIN-1培养基基础 用于分离小肠结肠炎耶尔森氏菌 (GB标准)
耶尔森氏菌琼脂培养基 用于分离小肠结肠炎耶尔森氏菌 (GB标准)
支原体培养基基础(含精氨酸) 用于培养支原体的基础培养基
支原体琼脂培养基 用于培养支原体的基础培养基
支原体肉汤培养基 用于培养支原体的基础培养基
支原体琼脂培养基(含精氨酸) 用于支原体的增菌培养
支原体肉汤培养基(不含琼脂和酚红) 用于支原体的增菌培养
风险提示:丁香通仅作为第三方平台,为商家信息发布提供平台空间。用户咨询产品时请注意保护个人信息及财产安全,合理判断,谨慎选购商品,商家和用户对交易行为负责。对于医疗器械类产品,请先查证核实企业经营资质和医疗器械产品注册证情况。
文献和实验佚名 我院于1997年6月~1999年10月使用左旋氧氟沙星治疗耐药细菌性痢疾50例, 疗效显著,现报告如下。 临床资料 一、病例选择 100例耐药细菌性痢疾均为我科住院及门诊患者,诊断按彭文伟主编的《 传染病学》第四版标准,拟大便培养分离出福氏痢疾杆菌证实。随机分治疗组50例,男2 8例,女22例,年龄13~68岁。入院前平均病程6.12天。对照组50
1.肠杆菌科细菌:氨苄西林、哌拉西林(或替卡西林、羧苄西林)、头孢唑啉、头孢呋辛、头孢他啶、头孢三嗪、头孢噻肟、环丙沙星(或诺氟沙星、氧氟沙星)、庆大霉素(或阿米卡星)、复方新诺明、呋喃妥因、氨曲南。 耐药菌株及产ESBL菌株加做:阿莫西林/CA、氨苄西林/SB、替卡西林/CA、哌拉西林/三唑巴坦、头孢吡肟、泰能、头孢他啶/CA、头孢噻肟/CA。 2 铜绿假单胞菌和不动杆菌:哌拉西林(或替卡西林、羧苄西林)、庆大霉素(或阿米卡星)、环丙沙星(或诺氟沙星、氧氟沙星)、头孢
佚名 [摘要] 目的:观察洛美沙星眼药水治疗眼部细菌性疾病的疗效。方法:166例,男性91例,女性75例,年龄37 a± s 16 a(18~65 a);结膜炎92例,角膜炎74例;洛美沙星组(104例,男性54例,女性50例),用0.3%洛美沙星眼药水;氧氟沙星组62例(男性35例,女性27例),用0.3%氧氟沙星眼药水,均6次.d-1,每次1滴,7 d为一个疗程;治疗
技术资料暂无技术资料 索取技术资料